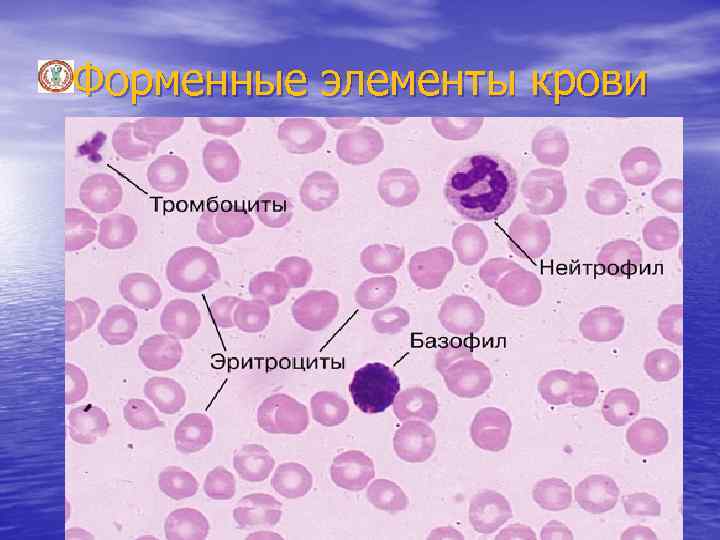
Форменные элементы крови

острые лейкозы(новая версия).ppt
- Количество слайдов: 54
 Острые лейкозы. Определение. Этиология и патогенез. Классификация острых лейкозов. Клинические проявления. Диагностика. Принципы лечения острых лейкозов. Лекция для студентов 4 курса по специальности «общая медицина» Лектор доцент кафедры внутренних болезней № 1 Краснова С. А.
Острые лейкозы. Определение. Этиология и патогенез. Классификация острых лейкозов. Клинические проявления. Диагностика. Принципы лечения острых лейкозов. Лекция для студентов 4 курса по специальности «общая медицина» Лектор доцент кафедры внутренних болезней № 1 Краснова С. А.
 Гемобластозы Онкогематология является одной из самых динамичных областей медицины, которая особенно активно развивалась в последние годы. Полученные, с помощью современных молекулярно-биохимических методов, результаты позволили объяснить структурные изменения генома клетки, ответственные за возникновение и темпы роста опухоли. Молекулярные исследования измененных участков хромосом привели к открытию генов, участвующих в развитии опухоли. Значительно расширены и уточнены представления о роли цитокинов в кроветворении. Изменились взгляды на патогенез лейкозов, изучены этапы дифференцировки нормальных кроветворных клеток и кроветворных клеток при лейкозах, что позволяет судить об уровне, на котором произошла малигнизация
Гемобластозы Онкогематология является одной из самых динамичных областей медицины, которая особенно активно развивалась в последние годы. Полученные, с помощью современных молекулярно-биохимических методов, результаты позволили объяснить структурные изменения генома клетки, ответственные за возникновение и темпы роста опухоли. Молекулярные исследования измененных участков хромосом привели к открытию генов, участвующих в развитии опухоли. Значительно расширены и уточнены представления о роли цитокинов в кроветворении. Изменились взгляды на патогенез лейкозов, изучены этапы дифференцировки нормальных кроветворных клеток и кроветворных клеток при лейкозах, что позволяет судить об уровне, на котором произошла малигнизация
 Гемобластозы Кроветворение (гемопоэз) – процесс образования и развития форменных элементов крови в кроветворных органах. Эритроциты, зернистые лейкоциты и тромбоциты образуются в костном мозге (эритропоэз, гранулопоэз, тромбоцитопоэз), лимфоциты – в костном мозге, селезенке и тимусе (лимфоцитопоэз), моноциты в костном мозге (моноцитопоэз). Все клетки крови имеют одну родоначальную форму – стволовую кроветворную клетку
Гемобластозы Кроветворение (гемопоэз) – процесс образования и развития форменных элементов крови в кроветворных органах. Эритроциты, зернистые лейкоциты и тромбоциты образуются в костном мозге (эритропоэз, гранулопоэз, тромбоцитопоэз), лимфоциты – в костном мозге, селезенке и тимусе (лимфоцитопоэз), моноциты в костном мозге (моноцитопоэз). Все клетки крови имеют одну родоначальную форму – стволовую кроветворную клетку
 Гемобластозы
Гемобластозы
Форменные элементы крови
Форменные элементы крови
 Лейкоцитарная формула
Лейкоцитарная формула
 Определение крови Кровь – внутренняя среда организма, жидкость, содержащая клеточные элементы, заключенная в кровеносной системе и пребывающая в постоянной циркуляции благодаря деятельности сердца и экстракардиальных факторов
Определение крови Кровь – внутренняя среда организма, жидкость, содержащая клеточные элементы, заключенная в кровеносной системе и пребывающая в постоянной циркуляции благодаря деятельности сердца и экстракардиальных факторов
 Функции крови Основные функции крови: • транспортная, осуществляется путем доставки на периферию к тканям и клеткам тела кислорода из легких, который необходим для окислительных процессов, а также питательных веществ из кишечника (белков, углеводов, жиров, витаминов, солей, воды); • удаление СО 2 и продуктов обмена через экскреторные системы (легкие, кишечник, печень, почки, кожу); • участие в процессах нейрогуморальной регуляции; • защитная (клеточный и гуморальный иммунитет); • участие в физико-химической регуляции гомеостаза (температурного, коллоидно-осмотического, кислотнощелочного, онкотического, химического)
Функции крови Основные функции крови: • транспортная, осуществляется путем доставки на периферию к тканям и клеткам тела кислорода из легких, который необходим для окислительных процессов, а также питательных веществ из кишечника (белков, углеводов, жиров, витаминов, солей, воды); • удаление СО 2 и продуктов обмена через экскреторные системы (легкие, кишечник, печень, почки, кожу); • участие в процессах нейрогуморальной регуляции; • защитная (клеточный и гуморальный иммунитет); • участие в физико-химической регуляции гомеостаза (температурного, коллоидно-осмотического, кислотнощелочного, онкотического, химического)
 Распределение крови в организме
Распределение крови в организме
 Гемобластозы - это опухолевый процесс, (новообразования), возникающий из клеток кроветворной ткани. Все лейкозы, как острые, так и хронические, имеют клоновый характер роста, то есть происходят из одной клетки, подвергшейся мутации. Скорость развития процесса зависит от доли активно пролиферирующих клеток, скорости гибели клеток и других факторов. Первичный лейкозный клон обладает генетической нестабильностью, в силу чего подвержен опухолевой прогрессии Гемобластозы подразделяются на 2 группы: 1) системные заболевания, диффузно поражающие кроветворную ткань - лейкозы; 2) регионарные заболевания лимфомы, которые образуют солидные опухоли
Гемобластозы - это опухолевый процесс, (новообразования), возникающий из клеток кроветворной ткани. Все лейкозы, как острые, так и хронические, имеют клоновый характер роста, то есть происходят из одной клетки, подвергшейся мутации. Скорость развития процесса зависит от доли активно пролиферирующих клеток, скорости гибели клеток и других факторов. Первичный лейкозный клон обладает генетической нестабильностью, в силу чего подвержен опухолевой прогрессии Гемобластозы подразделяются на 2 группы: 1) системные заболевания, диффузно поражающие кроветворную ткань - лейкозы; 2) регионарные заболевания лимфомы, которые образуют солидные опухоли
 Гемобластозы Лейкозы - полиэтиологические заболевания. В возникновении их могут быть повинны различные факторы, способные вызвать мутацию клеток кроветворной системы. Среди мутагенов следует назвать: - вирусы, - ионизирующее излучение (частота мутаций зависит непосредственно от дозы ионизирующей радиации. После атомного взрыва в Хиросиме и Нагасаки заболеваемость острым лейкозом и хроническим миелозом среди облученных возросла примерно в 7, 5 раз ), - ряд химических веществ (дибензантрацен, бензпирен, метилхолантрен, т. е. бластомогенные вещества). - «программированная клеточная смерть» или «апоптоз»
Гемобластозы Лейкозы - полиэтиологические заболевания. В возникновении их могут быть повинны различные факторы, способные вызвать мутацию клеток кроветворной системы. Среди мутагенов следует назвать: - вирусы, - ионизирующее излучение (частота мутаций зависит непосредственно от дозы ионизирующей радиации. После атомного взрыва в Хиросиме и Нагасаки заболеваемость острым лейкозом и хроническим миелозом среди облученных возросла примерно в 7, 5 раз ), - ряд химических веществ (дибензантрацен, бензпирен, метилхолантрен, т. е. бластомогенные вещества). - «программированная клеточная смерть» или «апоптоз»
 классификация лейкозов (ВОЗ 2001 год) 1. Опухоли из предшественников В-лимфоцитов В-лимфобластный лейкоз/лимфома из предшественников Вклеток (острый лимфобластный лейкоз из предшественников В-клеток), 2. Зрелые В-клеточные опухоли с фенотипом зрелых лимфоцитов) • Хронический лимфоцитарный лейкоз/лимфома из малых лимфоцитов • В-клеточный пролимфоцитарный лейкоз • Лимфоплазмоцитарная лимфома • Селезеночная лимфома маргинальной зоны • Волосатоклеточная лейкоз • Плазмоцитарная миелома • Моноклональная гаммапатия с неопределенным потенциалом • Солитарная плазмоцитома костей • Внекостная плазмоцитома
классификация лейкозов (ВОЗ 2001 год) 1. Опухоли из предшественников В-лимфоцитов В-лимфобластный лейкоз/лимфома из предшественников Вклеток (острый лимфобластный лейкоз из предшественников В-клеток), 2. Зрелые В-клеточные опухоли с фенотипом зрелых лимфоцитов) • Хронический лимфоцитарный лейкоз/лимфома из малых лимфоцитов • В-клеточный пролимфоцитарный лейкоз • Лимфоплазмоцитарная лимфома • Селезеночная лимфома маргинальной зоны • Волосатоклеточная лейкоз • Плазмоцитарная миелома • Моноклональная гаммапатия с неопределенным потенциалом • Солитарная плазмоцитома костей • Внекостная плазмоцитома
 классификация лейкозов (ВОЗ 2001 год) • Первичный амилоидоз • Болезнь тяжелых цепей • Экстранодальная В-клеточная лимфома маргинальной зоны • • (лимфома лимфоидной ткани, ассоциированной со слизистыми оболочками; MALT-лимфома) Нодальная В-клеточная лимфома маргинальной зоны Фолликулярная лимфома Лимфома из клеток зоны мантии Диффузная крупноклеточная В-клеточная лимфома Медиастинальная крупноклеточная В-клеточная лимфома Внутрисосудистая крупноклеточная В-клеточная лимфома Первичная лимфома серозных полостей Лимфома/лейкоз Беркитта
классификация лейкозов (ВОЗ 2001 год) • Первичный амилоидоз • Болезнь тяжелых цепей • Экстранодальная В-клеточная лимфома маргинальной зоны • • (лимфома лимфоидной ткани, ассоциированной со слизистыми оболочками; MALT-лимфома) Нодальная В-клеточная лимфома маргинальной зоны Фолликулярная лимфома Лимфома из клеток зоны мантии Диффузная крупноклеточная В-клеточная лимфома Медиастинальная крупноклеточная В-клеточная лимфома Внутрисосудистая крупноклеточная В-клеточная лимфома Первичная лимфома серозных полостей Лимфома/лейкоз Беркитта
 классификация лейкозов (ВОЗ 2001 год) III. В-клеточные лимфопролиферативные процессы с неопределенным опухолевым потенциалом 1. Лимфоматоидный гранулематоз 2. Посттрансплантационное лимфопролиферативное заболевание, полиморфноклеточное Т-КЛЕТОЧНЫЕ ОПУХОЛИ I. Опухоли из предшественников Т-лимфоцитов Т-лимфобластный лейкоз/лимфома из предшественников Тклеток (острый лимфобластный лейкоз из предшественников Тклеток).
классификация лейкозов (ВОЗ 2001 год) III. В-клеточные лимфопролиферативные процессы с неопределенным опухолевым потенциалом 1. Лимфоматоидный гранулематоз 2. Посттрансплантационное лимфопролиферативное заболевание, полиморфноклеточное Т-КЛЕТОЧНЫЕ ОПУХОЛИ I. Опухоли из предшественников Т-лимфоцитов Т-лимфобластный лейкоз/лимфома из предшественников Тклеток (острый лимфобластный лейкоз из предшественников Тклеток).
 классификация лейкозов (ВОЗ 2001 год) II. Т- и NK-клеточные опухоли с фенотипом зрелых лимфоцитов Лейкозы и первично диссеминированные лимфомы: 1. Т-клеточный пролимфоцитарный лейкоз 2. Т-клеточный лейкоз из крупных гранулярных лимфоцитов 3. Агрессивный NK-клеточный лейкоз 4. Т-клеточный лейкоз/лимфома взрослых Кожные лимфомы 1. Грибовидный микоз 2. Синдром Сезари 3. Первичная кожная крупноклеточная анапластическая лимфома 4. Лимфоматоидный папуллез
классификация лейкозов (ВОЗ 2001 год) II. Т- и NK-клеточные опухоли с фенотипом зрелых лимфоцитов Лейкозы и первично диссеминированные лимфомы: 1. Т-клеточный пролимфоцитарный лейкоз 2. Т-клеточный лейкоз из крупных гранулярных лимфоцитов 3. Агрессивный NK-клеточный лейкоз 4. Т-клеточный лейкоз/лимфома взрослых Кожные лимфомы 1. Грибовидный микоз 2. Синдром Сезари 3. Первичная кожная крупноклеточная анапластическая лимфома 4. Лимфоматоидный папуллез
 классификация лейкозов (ВОЗ 2001 год) III. Другие экстранодальные лимфомы 1. Экстранодальная NK/Т-клеточная лимфома, назальный тип 2. Т-клеточная лимфома типа энтеропатии 3. Гепатолиенальная Т-клеточная лимфома 4. Панникулитоподобная Т-клеточная лимфома подкожной клетчатки IV. Лимфомы лимфатических узлов 1. Ангиоиммунобластная Т-клеточная лимфома 2. Лимфома из клеток с иммунофенотипом периферических Тлимфоцитов, неуточненная 3. Анапластическая крупноклеточная лимфома V. Опухоль неопределенной дифференцировки 1. Бластная NK-клеточная лимфома
классификация лейкозов (ВОЗ 2001 год) III. Другие экстранодальные лимфомы 1. Экстранодальная NK/Т-клеточная лимфома, назальный тип 2. Т-клеточная лимфома типа энтеропатии 3. Гепатолиенальная Т-клеточная лимфома 4. Панникулитоподобная Т-клеточная лимфома подкожной клетчатки IV. Лимфомы лимфатических узлов 1. Ангиоиммунобластная Т-клеточная лимфома 2. Лимфома из клеток с иммунофенотипом периферических Тлимфоцитов, неуточненная 3. Анапластическая крупноклеточная лимфома V. Опухоль неопределенной дифференцировки 1. Бластная NK-клеточная лимфома
 классификация лейкозов (ВОЗ 2001 год) ЛИМФОМА ХОДЖКИНА Нодулярный тип лимфоидного преобладания II. Классическая лимфома Ходжкина 1. Нодулярный склероз 2. Смешанно-клеточный вариант 3. С большим количеством лимфоцитов 4. С истощением лимфоидной ткани
классификация лейкозов (ВОЗ 2001 год) ЛИМФОМА ХОДЖКИНА Нодулярный тип лимфоидного преобладания II. Классическая лимфома Ходжкина 1. Нодулярный склероз 2. Смешанно-клеточный вариант 3. С большим количеством лимфоцитов 4. С истощением лимфоидной ткани
 Острые лейкозы представляют собой гетерогенную группу опухолевых заболеваний системы крови - гемобластозов, которые характеризуются первичным поражением костного мозга морфологически незрелыми кроветворными (бластными) клетками с вытеснением ими нормальных элементов гемопоэза и инфильтрацией ими различных тканей и органов. Острые лейкозы - клональные (онкологические) заболевания, первично возникающие в костном мозге в результате мутации стволовой клетки крови. Следствием мутации является потеря потомками мутировавшей клетки способности к дифференцировке до зрелых клеток крови. Клеточным (морфологическим) субстратом острых лейкозов являются бластные клетки
Острые лейкозы представляют собой гетерогенную группу опухолевых заболеваний системы крови - гемобластозов, которые характеризуются первичным поражением костного мозга морфологически незрелыми кроветворными (бластными) клетками с вытеснением ими нормальных элементов гемопоэза и инфильтрацией ими различных тканей и органов. Острые лейкозы - клональные (онкологические) заболевания, первично возникающие в костном мозге в результате мутации стволовой клетки крови. Следствием мутации является потеря потомками мутировавшей клетки способности к дифференцировке до зрелых клеток крови. Клеточным (морфологическим) субстратом острых лейкозов являются бластные клетки
 Острые лейкозы – это довольно редкое заболевание и составляет лишь 3% злокачественных опухолей человека. Однако среди гемобластозов острые лейкозы занимают одно из первых мест по частоте встречаемости. При правильном и своевременном лечении прогноз для детей часто благоприятен. Как для опухолевых заболеваний, для острых лейкозов невозможно выделить специфический этиологический фактор. Среди мутагенов следует назвать вирусы, ионизирующее излучение, ряд химических веществ
Острые лейкозы – это довольно редкое заболевание и составляет лишь 3% злокачественных опухолей человека. Однако среди гемобластозов острые лейкозы занимают одно из первых мест по частоте встречаемости. При правильном и своевременном лечении прогноз для детей часто благоприятен. Как для опухолевых заболеваний, для острых лейкозов невозможно выделить специфический этиологический фактор. Среди мутагенов следует назвать вирусы, ионизирующее излучение, ряд химических веществ
 Острые лейкозы
Острые лейкозы
 Острые лейкозы Различают стадии острого лейкоза: 1. Начальная - оценивается ретроспективно. 2. Развернутый период с клиническими и гематологическими проявлениями. Здесь различаются: а) первая атака; б) рецидив болезни; в) второй рецидив и т. д. ; г) ремиссия. Признаки полной клинико-гематологической ремиссии: нормализация общего состояния больного; наличие в миелограмме не более 5% бластных клеток; в крови лейкоцитов не менее 5. 109/л; тромбоцитов не менее 100. 109/л; бластных элементов в периферической крови нет. Выздоровление-это полная клиникогематологическая ремиссия на протяжении 5 и более лет, 3. Терминальная - отсутствие эффекта от цитостатической терапии, угнетение нормального кроветворения Различаются 2 фазы болезни: а) алейкемическая (без выхода бластов в периферическую кровь); 6) лейкемическая (с выходом бластных клеток в периферическую кровь)
Острые лейкозы Различают стадии острого лейкоза: 1. Начальная - оценивается ретроспективно. 2. Развернутый период с клиническими и гематологическими проявлениями. Здесь различаются: а) первая атака; б) рецидив болезни; в) второй рецидив и т. д. ; г) ремиссия. Признаки полной клинико-гематологической ремиссии: нормализация общего состояния больного; наличие в миелограмме не более 5% бластных клеток; в крови лейкоцитов не менее 5. 109/л; тромбоцитов не менее 100. 109/л; бластных элементов в периферической крови нет. Выздоровление-это полная клиникогематологическая ремиссия на протяжении 5 и более лет, 3. Терминальная - отсутствие эффекта от цитостатической терапии, угнетение нормального кроветворения Различаются 2 фазы болезни: а) алейкемическая (без выхода бластов в периферическую кровь); 6) лейкемическая (с выходом бластных клеток в периферическую кровь)
 Клиническая картина острых лейкозов Клиническая картина одинакова для всех типов острых лейкозов. Начало заболевания может быть внезапным. Тяжёлое состояние больного может быть обусловлено выраженной интоксикацией, геморрагическим синдромом (результат тромбоцитопении), дыхательной недостаточностью (вследствие сдавления дыхательных путей увеличенными внутригрудными лимфатическими узлами)
Клиническая картина острых лейкозов Клиническая картина одинакова для всех типов острых лейкозов. Начало заболевания может быть внезапным. Тяжёлое состояние больного может быть обусловлено выраженной интоксикацией, геморрагическим синдромом (результат тромбоцитопении), дыхательной недостаточностью (вследствие сдавления дыхательных путей увеличенными внутригрудными лимфатическими узлами)
 Клиническая картина острых лейкозов
Клиническая картина острых лейкозов
 Клиническая картина острых лейкозов (синдромы) • Анемический синдром: бледность, одышка, сердцебиение, • • сонливость. Склонность к инфекциям (бактериальным, грибковым и вирусным). Геморрагический синдром. При осмотре выявляют петехии и экхимозы на коже (самопроизвольные, в местах инъекций, механического трения). Возможны интенсивные носовые и тяжёлые внутренние кровотечения (метроррагии, желудочнокишечные кровотечения, кровоизлияния в мозг). ДВС-синдром Гиперпластический (Лимфаденопатия. Характеристика: множественные, плотные, эластичные, округлые, могут быть спаяны друг с другом, разных размеров (от 1 до 8 см); пальпация безболезненна. Увеличение брыжеечных лимфатических узлов и гипертрофия червеобразного отростка как лимфоидного
Клиническая картина острых лейкозов (синдромы) • Анемический синдром: бледность, одышка, сердцебиение, • • сонливость. Склонность к инфекциям (бактериальным, грибковым и вирусным). Геморрагический синдром. При осмотре выявляют петехии и экхимозы на коже (самопроизвольные, в местах инъекций, механического трения). Возможны интенсивные носовые и тяжёлые внутренние кровотечения (метроррагии, желудочнокишечные кровотечения, кровоизлияния в мозг). ДВС-синдром Гиперпластический (Лимфаденопатия. Характеристика: множественные, плотные, эластичные, округлые, могут быть спаяны друг с другом, разных размеров (от 1 до 8 см); пальпация безболезненна. Увеличение брыжеечных лимфатических узлов и гипертрофия червеобразного отростка как лимфоидного
 Клиническая картина острых лейкозов (синдромы) Гипертрофия внутригрудных лимфатических узлов. Печень и селезёнка увеличены. Гипертрофия дёсен, лейкемиды кожи (специфические узелки). В средостение наблюдается гипертрофия тимуса, что может вызвать сдавление органов средостения). Признаки специфического поражения: • Интоксикация: лихорадка, снижение массы тела, снижение аппетита, слабость, усиленная потливость. • Болезненность костей (особенно трубчатых, позвоночника), артралгии
Клиническая картина острых лейкозов (синдромы) Гипертрофия внутригрудных лимфатических узлов. Печень и селезёнка увеличены. Гипертрофия дёсен, лейкемиды кожи (специфические узелки). В средостение наблюдается гипертрофия тимуса, что может вызвать сдавление органов средостения). Признаки специфического поражения: • Интоксикация: лихорадка, снижение массы тела, снижение аппетита, слабость, усиленная потливость. • Болезненность костей (особенно трубчатых, позвоночника), артралгии
 Клиническая картина острых лейкозов (синдромы) • Нейролейкемия. (поражение центральной нервной системы) возникает особенно часто при остром лимфобластном лейкозе и значительно ухудшает прогноз. Возникновение нейролейкемии обусловлено метастазированием лейкозных клеток в оболочки головного и спинного мозга или в вещество мозга (интратумор, прогностически более тяжёлый тип опухолевого роста). В неврологическом статусе возможны проявления различной тяжести - от лёгкой общемозговой симптоматики (головная боль) до очаговых поражений (нарушение сознания, нарушение зрения, дискоординация движений, дисфазия)
Клиническая картина острых лейкозов (синдромы) • Нейролейкемия. (поражение центральной нервной системы) возникает особенно часто при остром лимфобластном лейкозе и значительно ухудшает прогноз. Возникновение нейролейкемии обусловлено метастазированием лейкозных клеток в оболочки головного и спинного мозга или в вещество мозга (интратумор, прогностически более тяжёлый тип опухолевого роста). В неврологическом статусе возможны проявления различной тяжести - от лёгкой общемозговой симптоматики (головная боль) до очаговых поражений (нарушение сознания, нарушение зрения, дискоординация движений, дисфазия)
 Клиническая картина острых лейкозов (синдромы) Среди острых лейкозов чаще встречаются острый миелобластный и лимфобластный лейкозы
Клиническая картина острых лейкозов (синдромы) Среди острых лейкозов чаще встречаются острый миелобластный и лимфобластный лейкозы
 Острый миелобластный лейкоз Заболевание характеризуется прогрессирующим течением, выраженной интоксикацией и лихорадкой, рано наступающей клинико-гематологической декомпенсацией процесса в виде тяжелой анемии, умеренной интенсивностью геморрагических проявлений, частных язвенно-некротических поражений слизистых и кожи.
Острый миелобластный лейкоз Заболевание характеризуется прогрессирующим течением, выраженной интоксикацией и лихорадкой, рано наступающей клинико-гематологической декомпенсацией процесса в виде тяжелой анемии, умеренной интенсивностью геморрагических проявлений, частных язвенно-некротических поражений слизистых и кожи.
 Острый миелобластный лейкоз Основными молекулярными проявлениями, ведущими к формированию лейкемического клона при миелоидных лейкозах, являются либо возникновение специфических транслокаций, как правило, с вовлечением протоонкогенов, либо мутации генов, участвующих в контроле пролиферации и дифференцировки миелоидной ткани. Для миелоидных опухолей наиболее характерными являются реципрокные транслокации, при которых происходит обмен генетическим материалом между различными хромосомами с образованием патологических хромосомных структур. Самой известной из этих хромосом является Филадельфийская хромосома. В периферической крови и костном мозге преобладают миелобласты
Острый миелобластный лейкоз Основными молекулярными проявлениями, ведущими к формированию лейкемического клона при миелоидных лейкозах, являются либо возникновение специфических транслокаций, как правило, с вовлечением протоонкогенов, либо мутации генов, участвующих в контроле пролиферации и дифференцировки миелоидной ткани. Для миелоидных опухолей наиболее характерными являются реципрокные транслокации, при которых происходит обмен генетическим материалом между различными хромосомами с образованием патологических хромосомных структур. Самой известной из этих хромосом является Филадельфийская хромосома. В периферической крови и костном мозге преобладают миелобласты
 Острый миелобластный лейкоз
Острый миелобластный лейкоз
 Острый лимфобластный лейкоз чаще встречается у детей и у лиц молодого возраста. Характеризуется увеличение какой-либо группы лимфоузлов, селезенки. Самочувствие больных не страдает, интоксикация выражена умеренно, анемия незначительная. Геморрагический синдром часто отсутствует. Больные жалуются на боли в костях. Острый лимфобластный лейкоз отличается частотой неврологических проявлений (нейролейкемия). В периферической крови и в пунктате присутствуют лимфобласты (молодые крупные клетки с округлым ядром)
Острый лимфобластный лейкоз чаще встречается у детей и у лиц молодого возраста. Характеризуется увеличение какой-либо группы лимфоузлов, селезенки. Самочувствие больных не страдает, интоксикация выражена умеренно, анемия незначительная. Геморрагический синдром часто отсутствует. Больные жалуются на боли в костях. Острый лимфобластный лейкоз отличается частотой неврологических проявлений (нейролейкемия). В периферической крови и в пунктате присутствуют лимфобласты (молодые крупные клетки с округлым ядром)
 Острый лимфобластный лейкоз В
Острый лимфобластный лейкоз В
 Острые лейкозы Верификация диагноза должна основываться на следующей картине: • цитоморфологической (выявление бластов), • цитохимической, • цитогенетической • на иммунофенотипировании бластных клеток (выявление кластеров дифференцировки (СД-маркеров)
Острые лейкозы Верификация диагноза должна основываться на следующей картине: • цитоморфологической (выявление бластов), • цитохимической, • цитогенетической • на иммунофенотипировании бластных клеток (выявление кластеров дифференцировки (СД-маркеров)
 Острые лейкозы (морфологический метод)
Острые лейкозы (морфологический метод)
 Диагностика острых лейкозов
Диагностика острых лейкозов
 Диагностика острых лейкозов Анализ крови: нормохромная нормоцитарная анемия; количество лейкоцитов может быть различным низким (ниже 5. 109/л), нормальным (от 5. 109/л до 20. 109/л. ), повышенным (свыше 20. 109/л. , достигая в некоторых случаях 200. 109/л); нейтропения (не зависит от общего количества лейкоцитов); абсолютный лимфоцитоз; тромбоцитопения (присутствует почти всегда); «лейкемический провал» , что означает присутствие бластов, зрелых форм на фоне отсутствия промежуточных форм; при остром миелобластном лейкозе можно обнаружить азурофильные гранулы и палочки Ауэра. Лейкопенический вариант острого лейкоза встречается почти у 50% больных
Диагностика острых лейкозов Анализ крови: нормохромная нормоцитарная анемия; количество лейкоцитов может быть различным низким (ниже 5. 109/л), нормальным (от 5. 109/л до 20. 109/л. ), повышенным (свыше 20. 109/л. , достигая в некоторых случаях 200. 109/л); нейтропения (не зависит от общего количества лейкоцитов); абсолютный лимфоцитоз; тромбоцитопения (присутствует почти всегда); «лейкемический провал» , что означает присутствие бластов, зрелых форм на фоне отсутствия промежуточных форм; при остром миелобластном лейкозе можно обнаружить азурофильные гранулы и палочки Ауэра. Лейкопенический вариант острого лейкоза встречается почти у 50% больных
 Диагностика острых лейкозов Миелограмма (количественное определение всех клеточных форм костного мозга) получается при стернальной пункции или трепанобиопсии подвздошной кости: увеличение содержания бластных клеток от 20% и до тотального бластоза. Морфология бластов различна в зависимости от типа лейкоза. Отмечается увеличение промежуточных форм, лимфоцитоз, красный росток кроветворения угнетён (за исключением острого эритромиелоза), мегакариоциты отсутствуют или их количество незначительно (за исключением острого мегакариобластного лейкоза)
Диагностика острых лейкозов Миелограмма (количественное определение всех клеточных форм костного мозга) получается при стернальной пункции или трепанобиопсии подвздошной кости: увеличение содержания бластных клеток от 20% и до тотального бластоза. Морфология бластов различна в зависимости от типа лейкоза. Отмечается увеличение промежуточных форм, лимфоцитоз, красный росток кроветворения угнетён (за исключением острого эритромиелоза), мегакариоциты отсутствуют или их количество незначительно (за исключением острого мегакариобластного лейкоза)
 Диагностика острых лейкозов Цитохимическое исследование - основной метод диагностики форм острых лейкозов. Его проводят с целью выявления ферментов, специфических для различных бластов. Цитохимические методы представляют собой достаточно простые, хорошо воспроизводимые, не требующие сложной аппаратуры методики, которые могут быть освоены в любой лаборатории
Диагностика острых лейкозов Цитохимическое исследование - основной метод диагностики форм острых лейкозов. Его проводят с целью выявления ферментов, специфических для различных бластов. Цитохимические методы представляют собой достаточно простые, хорошо воспроизводимые, не требующие сложной аппаратуры методики, которые могут быть освоены в любой лаборатории
 Основные цитохимические характеристики бластных клеток при острых лейкозах Лимфобластная форма лейкоза: Пероксидаза -, Липиды -, PAS-реакция + крупногрануллированная, Неспецифическая эстераза -, Хлорацетат Эстераза -, Кислая фосфатаза в отдельных клетках
Основные цитохимические характеристики бластных клеток при острых лейкозах Лимфобластная форма лейкоза: Пероксидаза -, Липиды -, PAS-реакция + крупногрануллированная, Неспецифическая эстераза -, Хлорацетат Эстераза -, Кислая фосфатаза в отдельных клетках
 Основные цитохимические характеристики бластных клеток при острых лейкозах Миелобластная форма лейкоза: Пероксидаза +, Липиды +, PAS-реакция + диффузная, Неспецифическая эстераза слабо +, Хлорацетат Эстераза +, Кислая фосфатаза +
Основные цитохимические характеристики бластных клеток при острых лейкозах Миелобластная форма лейкоза: Пероксидаза +, Липиды +, PAS-реакция + диффузная, Неспецифическая эстераза слабо +, Хлорацетат Эстераза +, Кислая фосфатаза +
 Основные цитохимические характеристики бластных клеток при острых лейкозах Монобластная форма лейкоза: Пероксидаза слабо + или отрицат, Липиды слабо + или отрицат, PAS-реакция + мелкогрануллированная , Неспецифическая эстераза +, Хлорацетат Эстераза _, Кислая фосфатаза +
Основные цитохимические характеристики бластных клеток при острых лейкозах Монобластная форма лейкоза: Пероксидаза слабо + или отрицат, Липиды слабо + или отрицат, PAS-реакция + мелкогрануллированная , Неспецифическая эстераза +, Хлорацетат Эстераза _, Кислая фосфатаза +
 Основные цитохимические характеристики бластных клеток при острых лейкозах Промиелоцитарная форма лейкоза: Пероксидаза слабо + или отрицат, Липиды слабо + или отрицат, PAS-реакция + диффузная , Неспецифическая эстераза +, Хлорацетат Эстераза _, Кислая фосфатаза +
Основные цитохимические характеристики бластных клеток при острых лейкозах Промиелоцитарная форма лейкоза: Пероксидаза слабо + или отрицат, Липиды слабо + или отрицат, PAS-реакция + диффузная , Неспецифическая эстераза +, Хлорацетат Эстераза _, Кислая фосфатаза +
 Основные цитохимические характеристики бластных клеток при острых лейкозах Острый эритромиелоз: Пероксидаза слабо + или отрицат, Липиды слабо + или отрицат, PAS-реакция + диффузная , Неспецифическая эстераза +, Хлорацетат Эстераза +, Кислая фосфатаза +
Основные цитохимические характеристики бластных клеток при острых лейкозах Острый эритромиелоз: Пероксидаза слабо + или отрицат, Липиды слабо + или отрицат, PAS-реакция + диффузная , Неспецифическая эстераза +, Хлорацетат Эстераза +, Кислая фосфатаза +
 Основные цитохимические характеристики бластных клеток при острых лейкозах Недифференцированная форма лейкоза: Пероксидаза отрицат, Липиды слабо отрицат, PAS-реакция отрицат, Неспецифическая эстераза отрицат, Хлорацетат Эстераза отрицат, Кислая фосфатаза отрицат
Основные цитохимические характеристики бластных клеток при острых лейкозах Недифференцированная форма лейкоза: Пероксидаза отрицат, Липиды слабо отрицат, PAS-реакция отрицат, Неспецифическая эстераза отрицат, Хлорацетат Эстераза отрицат, Кислая фосфатаза отрицат
 Диагностика острых лейкозов Иммунофенотипирование бластов проводят автоматизированным методом на проточном цитофлюориметре или иммуноферментным методом на стекле с использованием световой микроскопии. Последний имеет то преимущество, что его можно проводить параллельно с цитохимическим исследованием. Иммунофенотипирование позволяет определить с помощью моноклональных антител наличие или отсутствие кластеров дифференцировки бластных клеток (CD-маркёры). Его проведение в первую очередь необходимо для точной диагностики острого лимфолейкоза, а также в трудных случаях дифференциальной диагностики острых лимфобластных и миелобластных лейкозов
Диагностика острых лейкозов Иммунофенотипирование бластов проводят автоматизированным методом на проточном цитофлюориметре или иммуноферментным методом на стекле с использованием световой микроскопии. Последний имеет то преимущество, что его можно проводить параллельно с цитохимическим исследованием. Иммунофенотипирование позволяет определить с помощью моноклональных антител наличие или отсутствие кластеров дифференцировки бластных клеток (CD-маркёры). Его проведение в первую очередь необходимо для точной диагностики острого лимфолейкоза, а также в трудных случаях дифференциальной диагностики острых лимфобластных и миелобластных лейкозов
 Лечение острых лейкозов • • Основные направления терапии Специфическая химиотерапия направлена на достижение и закрепление ремиссии заболевания, состоит из нескольких этапов, различна для лимфобластного и миелобластного лейкозов. Расчёт доз производят на площадь поверхности тела по таблице Дюбуа с учётом массы тела и роста. Сопутствующая терапия. Её проводят для борьбы с инфекциями, обусловленными агранулоцитозом, для снижения интоксикации при лизисе опухолевого субстрата, для уменьшения побочных токсических эффектов химиотерапевтических препаратов. Заместительная терапия необходима при угрожающей тромбоцитопении, тяжёлой анемии, нарушениях свертывания крови. Трансплантация стволовых кроветворных клеток или костного мозга
Лечение острых лейкозов • • Основные направления терапии Специфическая химиотерапия направлена на достижение и закрепление ремиссии заболевания, состоит из нескольких этапов, различна для лимфобластного и миелобластного лейкозов. Расчёт доз производят на площадь поверхности тела по таблице Дюбуа с учётом массы тела и роста. Сопутствующая терапия. Её проводят для борьбы с инфекциями, обусловленными агранулоцитозом, для снижения интоксикации при лизисе опухолевого субстрата, для уменьшения побочных токсических эффектов химиотерапевтических препаратов. Заместительная терапия необходима при угрожающей тромбоцитопении, тяжёлой анемии, нарушениях свертывания крови. Трансплантация стволовых кроветворных клеток или костного мозга
 Лечение острых лейкозов Лечение химиотерапевтическими препаратами начинают после установления типа (лимфобластный, миелобластный) и варианта острого лейкоза. Все острые лейкозы лечатся индивидуально по строго соблюдаемым протоколам (программам) полихимиотерапии, которые создаются на основе результатов исследований объединенных гематологических научных групп в различных странах. Лечение миелобластного и лимфобластного лейкозов различное
Лечение острых лейкозов Лечение химиотерапевтическими препаратами начинают после установления типа (лимфобластный, миелобластный) и варианта острого лейкоза. Все острые лейкозы лечатся индивидуально по строго соблюдаемым протоколам (программам) полихимиотерапии, которые создаются на основе результатов исследований объединенных гематологических научных групп в различных странах. Лечение миелобластного и лимфобластного лейкозов различное
 Лечение острого лимфобластного лейкоза проводят соответственно его иммунофенотипическому варианту, данных цитогенетики. Протоколы лечения обязательно включают в свой состав L-аспарагиназу в сочетании с винкристином, рубомицином, циклофосфамидом, цитарабином, меркаптопурином, преднизолоном, а также применяют 6 люмбальных пункций с введением метотрексата, преднизолона и цитарабина
Лечение острого лимфобластного лейкоза проводят соответственно его иммунофенотипическому варианту, данных цитогенетики. Протоколы лечения обязательно включают в свой состав L-аспарагиназу в сочетании с винкристином, рубомицином, циклофосфамидом, цитарабином, меркаптопурином, преднизолоном, а также применяют 6 люмбальных пункций с введением метотрексата, преднизолона и цитарабина
 Лечение острого лимфобластного лейкоза Для применения того или иного протокола лечения, выделяют группы стандартного и высокого риска острого лимфобластного лейкоза. Сроки лечения и дозы препаратов зависят также от стадии (индукция ремиссии, консолидация – закрепление, редукция ремиссии, поддерживающая терапия). В группе высокого риска лечение длительное, большими дозами и поддерживающая терапия не проводится
Лечение острого лимфобластного лейкоза Для применения того или иного протокола лечения, выделяют группы стандартного и высокого риска острого лимфобластного лейкоза. Сроки лечения и дозы препаратов зависят также от стадии (индукция ремиссии, консолидация – закрепление, редукция ремиссии, поддерживающая терапия). В группе высокого риска лечение длительное, большими дозами и поддерживающая терапия не проводится
 Лечение острого миелобластного лейкоза Программой лечения острого миелобластного лейкоза является « 7+3» - «золотой стандарт» полихимиотерапии. Индукция ремиссии: цитарабин 7 дней + рубомицин 3 дня (два курса), консолидация ремиссии: 2 курса « 7+3» , Поддерживающая: « 7+3» с интервалом в 6 недель
Лечение острого миелобластного лейкоза Программой лечения острого миелобластного лейкоза является « 7+3» - «золотой стандарт» полихимиотерапии. Индукция ремиссии: цитарабин 7 дней + рубомицин 3 дня (два курса), консолидация ремиссии: 2 курса « 7+3» , Поддерживающая: « 7+3» с интервалом в 6 недель
 Лечение острых лейкозов Трансплантация костного мозга успешно используется для лечения пациентов с лейкозом, апластической анемией, лимфомами (лимфома Ходжкина, множественная миелома, иммунная недостаточность, нейробластомы), и при некоторых солидных опухолях (рак груди и рак яичников). Здоровые стволовые клетки пересаживаются реципиенту для возобновления нормального функционирования системы кроветворения
Лечение острых лейкозов Трансплантация костного мозга успешно используется для лечения пациентов с лейкозом, апластической анемией, лимфомами (лимфома Ходжкина, множественная миелома, иммунная недостаточность, нейробластомы), и при некоторых солидных опухолях (рак груди и рак яичников). Здоровые стволовые клетки пересаживаются реципиенту для возобновления нормального функционирования системы кроветворения
 Лечение острых лейкозов Трансплантация костного мозга, несмотря на название, на самом деле является трансплантацией стволовых клеток костного мозга. Пересадка костного мозга является очень интенсивным методом лечения, поэтому возраст пациента и общее состояние здоровья должны приниматься во внимание при решении вопроса трансплантации. К примеру, обычно пациент должен не старше 65 лет для прохождения такого лечения
Лечение острых лейкозов Трансплантация костного мозга, несмотря на название, на самом деле является трансплантацией стволовых клеток костного мозга. Пересадка костного мозга является очень интенсивным методом лечения, поэтому возраст пациента и общее состояние здоровья должны приниматься во внимание при решении вопроса трансплантации. К примеру, обычно пациент должен не старше 65 лет для прохождения такого лечения
 Лечение острых лейкозов Аллотрансплантация костного мозга впервые была успешно проведена в конце 60 -х гг. ХХ-го столетия, а в 70 -х годах получила всеобщее признание. • Аллотрансплантация - это пересадка стволовых клеток от совместимого по системе HLA (родственного или неродственного) донора. • Аутотрансплантация подразумевает использование заранее заготовленных собственных стволовых клеток крови или костного мозга реципиента, забор которых производится до начала лечения. • Существует также гаплоидентичная пересадка - пересадка с 50% совместимостью, как правило, от близкого родственника
Лечение острых лейкозов Аллотрансплантация костного мозга впервые была успешно проведена в конце 60 -х гг. ХХ-го столетия, а в 70 -х годах получила всеобщее признание. • Аллотрансплантация - это пересадка стволовых клеток от совместимого по системе HLA (родственного или неродственного) донора. • Аутотрансплантация подразумевает использование заранее заготовленных собственных стволовых клеток крови или костного мозга реципиента, забор которых производится до начала лечения. • Существует также гаплоидентичная пересадка - пересадка с 50% совместимостью, как правило, от близкого родственника
 Острые лейкозы СПАСИБО ЗА ВНИМАНИЕ
Острые лейкозы СПАСИБО ЗА ВНИМАНИЕ


